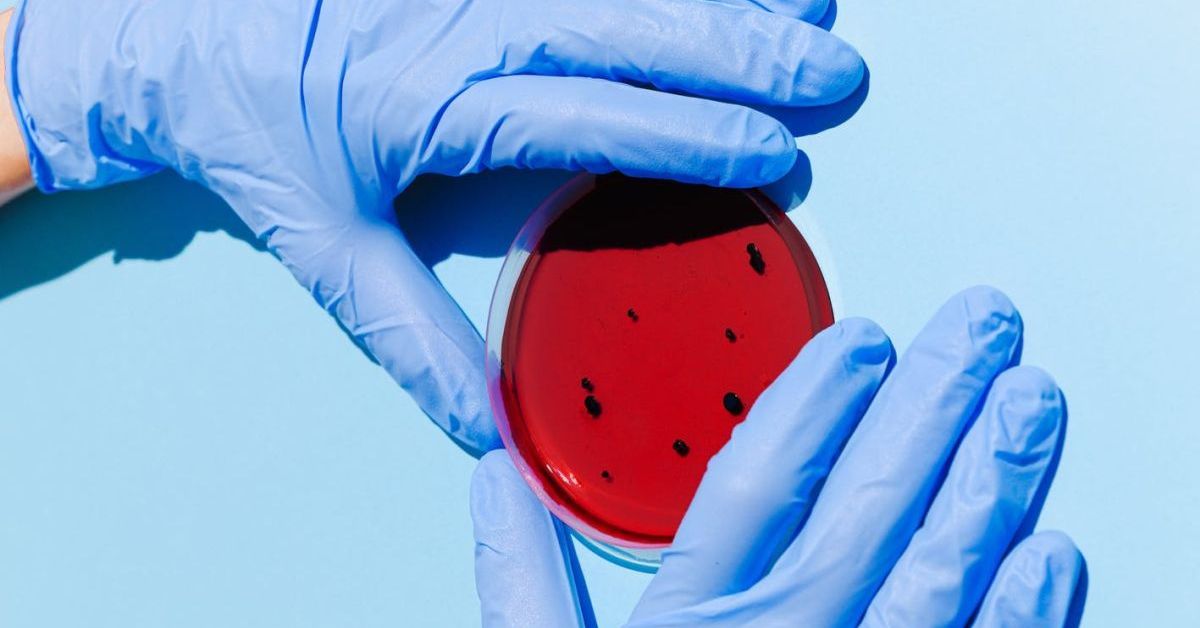

juste un instant
Επιφανές μέλος


Σημείωση: Το μήνυμα αυτό γράφτηκε 5 χρόνια πριν. Ο συντάκτης του πιθανόν να έχει αλλάξει απόψεις έκτοτε.
chester20080
Επιφανές μέλος


Ρε παιδια ενα break, πάτε και μια τουαλέτα, δεν προλαβαινω ουτε να διαβασω τον ορισμο του spam στη wikipedia και μου ρχεται ειδοποιηση!
Θελετε να τα πειτε τα δυο σας πρωτα και μετα να γραψετε εδω πιο ολοκληρωμενα ποστ και οχι τοσο debate φαση?


Κορωνοϊός Ιταλία: 20 γιατροί έχασαν τη ζωή τους - 4.800 υγειονομικοί αρρώστησαν - Iatropedia

Οι εργαζόμενοι στην Υγεία αποτελούν το 8,1% των κρουσμάτων. Οι περισσότεροι από αυτούς είναι γιατροί και νοσηλευτές.
Σημείωση: Το μήνυμα αυτό γράφτηκε 5 χρόνια πριν. Ο συντάκτης του πιθανόν να έχει αλλάξει απόψεις έκτοτε.
Gate4
Επιφανές μέλος


ουπς
Σημείωση: Το μήνυμα αυτό γράφτηκε 5 χρόνια πριν. Ο συντάκτης του πιθανόν να έχει αλλάξει απόψεις έκτοτε.


"Δεδομένου ότι δεν έχουμε αρκετά επιδημιολογικά στοιχεία στα χέρια μας για τον ιό μέχρι στιγμής, θεωρείτε ότι η καραντίνα είναι λάθος κίνηση;
Η καραντίνα είναι η σωστή κίνηση σε αυτή τη φάση. (...) Η καραντίνα ολόκληρου του πληθυσμού είναι λύση απελπισίας, αλλά και πάλι είναι σωστή εάν δεν έχεις δεδομένα και πας στα τυφλά. (...)
Εναλλακτικά τι θα μπορούσε να γίνει; Να περιμένουμε να βγουν περισσότερα δεδομένα και μετά να δράσουμε ως χώρες;
Όχι, η δράση πρέπει να είναι άμεση και αποφασιστική. Αλλά και η συλλογή των δεδομένων πρέπει να είναι εξίσου άμεση και αποφασιστική, για να καθοδηγήσει γρήγορα τα επόμενα βήματα. (...)"
Στο μόνο, δηλαδή, που κάνει κριτική είναι ότι δεν υπάρχει καμία ερεύνα για να βγει μια πιο αξιόπιστη στατιστική, καθώς τα τεστ συνεχίζουν να γίνονται σε όσους νοσούν (βαριά). Και άρα από τη στιγμή που δεν ξέρεις σε τι στάδιο βρίσκεσαι, δεν μπορείς να έχεις κάποιο έλεγχο και να κάνεις σωστές κινήσεις. Θα είμαστε εν δυνάμει άρρωστοι επ' αόριστον; Δεν έχουμε εικόνα καλή για το ποσοστό που νοσεί στη χώρα μας, ούτε τις ηλικιακές ομάδες, ούτε τίποτα.
Σημείωση: Το μήνυμα αυτό γράφτηκε 5 χρόνια πριν. Ο συντάκτης του πιθανόν να έχει αλλάξει απόψεις έκτοτε.
chester20080
Επιφανές μέλος



Κορωνοϊός: Στους 20 οι νεκροί στην Ελλάδα - 743 τα κρούσματα

40χρονη διαβασα ήταν η 20η ασθενης που κατεληξε..
Σημείωση: Το μήνυμα αυτό γράφτηκε 5 χρόνια πριν. Ο συντάκτης του πιθανόν να έχει αλλάξει απόψεις έκτοτε.
fockos
Επιφανές μέλος


Σημείωση: Το μήνυμα αυτό γράφτηκε 5 χρόνια πριν. Ο συντάκτης του πιθανόν να έχει αλλάξει απόψεις έκτοτε.
*Serena*
Τιμώμενο Μέλος


Σημείωση: Το μήνυμα αυτό γράφτηκε 5 χρόνια πριν. Ο συντάκτης του πιθανόν να έχει αλλάξει απόψεις έκτοτε.
chester20080
Επιφανές μέλος


Μπορεί κάποιος να μου πει πού κανει λαθος αυτός ο περιβόητος Φαίδων Βόβολης?

Διαβάστε το ποστ του Φαίδων Βόβολη που διαγράφηκε και βγάλτε τα συμπεράσματά σας…

Είχε κάνει και ένα άλλο post πριν καμιά βδομάδα:
Bei Facebook anmelden
Σημείωση: Το μήνυμα αυτό γράφτηκε 5 χρόνια πριν. Ο συντάκτης του πιθανόν να έχει αλλάξει απόψεις έκτοτε.
Guest 451212
Επισκέπτης


Σημείωση: Το μήνυμα αυτό γράφτηκε 5 χρόνια πριν. Ο συντάκτης του πιθανόν να έχει αλλάξει απόψεις έκτοτε.
Scandal
Διαχειριστής


Σημείωση: Το μήνυμα αυτό γράφτηκε 5 χρόνια πριν. Ο συντάκτης του πιθανόν να έχει αλλάξει απόψεις έκτοτε.
fockos
Επιφανές μέλος


Αν η κοινή γρίπη έχει περισσότερα κρούσματα και θανάτους από τον covi19 προφανώς και κατ αναλογία χρόνου τότε πως και δεν κατέρρεαν τα συστήματα υγείας των χωρών;
Υπήρχε μια έξαρση αλλά την γρίπη την περίμενουν, αυτό είναι κάτι νέο και δεν ήξεραν πως θα προχωρήσει (χωρίς ειδική θεραπεία, χωρίς εμβόλιο). Γενικά ομως η γρίπη προκαλεί προβλήματα και πεθαίνουν πολλοί για αυτό εγώ αρχικα έλεγα για παραπληροφόρηση. Πιστευα πως τα κρούσματα στην Ελλαδα θα φτάνανε και θα ειχαμε πολλά κρούσματα αυτό που δεν υπολόγησα ήταν το ποσοστό που κάνει πνευμονία σε σύγκριση με την απλή γρίπη. Ακόμα έχω απόψεις που μπορώ να υπερασπιστώ αυτά που έλεγα αλλά δε το κάνω τώρα γιατί τα πράγματα είναι σοβαρά.
_________

Πανδημία κορονοϊού 2020
Τώρα βγήκε ως οδηγία στα περιστατικά με επιβεβαιωμένο κορονοιό να καλύπτονται με zithromax (άλλη μια μακρολίδη)

Κορονοϊός: Δοκιμή πειραματικού φαρμάκου σε 1.000 άτομα στη Νέα Υόρκη

φυσικά το zithromax δε μπαίνει για αντιμετώπιση του ιού αλλά για πρόληψη επιπλεγμένης λοίμωξης και η υδροξυχλωροκίλη δίνεται ως ανοσοτροποιητικό.
Δεν είναι πειραματική θεραπεία αυτή (μη νομίζετε ότι κάνουν πειράματα στους ασθενείς στην ΜΕΘ) .... είναι συμπτωματική και εφαρμόζεται στην Ελλάδα.
Σημείωση: Το μήνυμα αυτό γράφτηκε 5 χρόνια πριν. Ο συντάκτης του πιθανόν να έχει αλλάξει απόψεις έκτοτε.
akikos
Επιφανές μέλος


Σημείωση: Το μήνυμα αυτό γράφτηκε 5 χρόνια πριν. Ο συντάκτης του πιθανόν να έχει αλλάξει απόψεις έκτοτε.
Valder
Τιμώμενο Μέλος



Σημείωση: Το μήνυμα αυτό γράφτηκε 5 χρόνια πριν. Ο συντάκτης του πιθανόν να έχει αλλάξει απόψεις έκτοτε.
Πουπουλίνα
Επιφανές μέλος


Δεν υπάρχει αυτό με την γρίπη δεν έχει καμία σχέση με τη γρίπη κάθε χρόνο και αυτό εδώ, ξαναλέω δεν βλέπουμε κάθε χρόνο να καταρρέουν τα συστήματα υγείας ούτε μας το κρύβει κανένας.
Και όσες χώρες άργησαν να λάβουν μέτρα καθώς ήταν διστακτικές για οικονομικούς λόγους και κάποιες εξέταζαν την ανοσία της αγέλης το μετάνιωσαν και έκαναν κωλοτούμπα και θα το μετανιώσουν ακόμα περισσότερο.Διότι αργησαν να τα πάρουν. Επίσης κάπου πήρε το αυτί μου ότι και η Σουηδία πλέον μπαίνει σε αυτή τη φάση αλλά δεν θυμάμαι που το είδα.Αν το βρω θα το βάλω.Ίσως να το άκουσα και στην τιβι.
Οπότε καλές αυτές οι θεωρίες αλλά άχρηστες πλεον διότι τις διαψεύδει η πραγματικότητα που ήδη ζούμε και όχι μελλοντικό σενάριο.
Και πάνω που οι έρμοι είχαν μια μικρή αισιοδοξία.Δυστυχώς...
Κορονοϊός: 743 νεκροί σε μια ημέρα στην Ιταλία - 6.820 συνολικά
Ο συνολικός αριθμός των περιστατικών κορονοϊού στην Ιταλία είναι 69.176. Οι νεκροί έφτασαν τους 6.820. Παράλληλα, 8.326 άνθρωποι έχουν ιαθεί. Χθες το σύνολο κρουσμάτων του κορονοϊού ήταν 63.927 και είχαν χάσει την ζωή τους, συνολικά, 6.077 άνθρωποι ενώ 7.432 είχαν ιαθεί.
Το τελευταίο εικοσιτετράωρο , δηλαδή, έχασαν την ζωή τους 743 ασθενείς και καταγράφηκαν 5.249 νέα κρούσματα. 894 ασθενείς έγιναν αρνητικοί στον ιό. 3.396 ασθενείς βρίσκονται σε μονάδες εντατικής θεραπείας και, συνολικά, 21.937 έχουν εισαχθεί σε νοσοκομείο. Για 28.697 έχει αποφασιστεί ο κατ΄οίκον περιορισμός.
Στην Λομβαρδία τα συνολικά περιστατικά είναι 30.703 και οι νεκροί 4.178 . Στην Εμίλια Ρομάνια τα κρούσματα είναι 9.254 με τους νεκρούς να έχουν φτάσει τους 985. Στην περιφέρεια Βένετο, οι θετικοί στον ιό είναι 5.948, με 216 νεκρούς. Σε σχέση με το προηγούμενο εικοσιτετράωρο, δυστυχώς, αυξάνεται και πάλι ο ρυθμός μετάδοσης του ιού, αλλά και ο αριθμός των νεκρών.
Πηγή: ΑΠΕ-ΜΠΕ
![]()
Κορονοϊός: 743 νεκροί σε μια ημέρα στην Ιταλία - 6.820 συνολικά
Ο συνολικός αριθμός των περιστατικών κορονοϊού στην Ιταλία είναι 69.176. Οι νεκροί...www.enikos.gr
Η οποία και πέθανε πριν πάει νοσοκομείο διότι τον ΕΟΔΥ και δεν πήγε.
Κορονοϊός: Τι είπε ο Σωτήρης Τσιόδρας για τον θάνατο της 40χρονης στην Καστοριά - ΒΙΝΤΕΟ
Στον θάνατο της 40χρονης στην Καστοριά αναφέρθηκε κατά τη διάρκεια της συνέντευξης Τύπου ο Σωτήρης Τσιόδρας μετά από ερώτηση που δέχθηκε από δημοσιογράφο. "Λίγα λεπτά πριν μπω στην αίθουσα με ενημέρωσαν για έναν θάνατο μιας νεαρής συμπολίτισσας μας, σε επαρχιακή πόλη της Βόρειας Ελλάδας, η οποία έμεινε σπίτι, πέθανε σπίτι και διεγνώσθη μετά θάνατον με τον ιό", τόνισε ο κ. Τσιόδρας και πρόσθεσε:
"Έχει πολύ μεγάλη σημασία για τους ανθρώπους που μένουν σπίτι να έχουν επικοινωνία με τον γιατρό τους, ιδιαίτερα αν έχουν κάποιοι υποκείμενο πρόβλημα υγείας. Μου είπαν τηλεφωνικά ότι υπήρχε κάποιο υποκείμενο πρόβλημα υγείας. Το χρόνιο αναπνευστικό νόσημα, είναι χρόνιο πρόβλημα υγείας. Δεν το έχω επιβεβαιώσει".

Κορονοϊός: Τι είπε ο Σωτήρης Τσιόδρας για τον θάνατο της 40χρονης στην Καστοριά - ΒΙΝΤΕΟ
Σκ@τά στο ίσιωμα δηλαδή.
Αν είχε κάτι αυτό δεν είναι επιβεβαιωμένο όπως και ο ίδιος παραδέχεται.Για άσθμα λένε.
Παρόλα αυτά είπαν στην τιβι ότι είχε επικοινωνήσει η γυναίκα και της είπαν να μείνει σπίτι.
Μία γυναίκα ηλικίας 40 ετών και μητέρα τριών παιδιών είναι το νεαρότερο θύμα του κορονοϊού στη χώρα μας. Η γυναίκα απεβίωσε πριν από μερικές μέρες στο σπίτι της σε απομακρυσμένο οικισμό της Καστοριάς και σύμφωνα με πληροφορίες ταλαιπωρούνταν από άσθμα.
Όπως αναφέρουν τα ρεπορτάζ, η 40χρονη είχε παρουσιάσει συμπτώματα σχετικό με τον ιό και συγκεκριμένα πυρετό. Φέρεται να επικοινώνησε με τον ΕΟΔΥ και έλαβε τη σύσταση να παραμείνει σπίτι της απομονωμένη. Ωστόσο, στην πορεία παρουσίασε επιδείνωση της υγείας της, κλήθηκε ασθενοφόρο, αλλά σύμφωνα με πληροφορίες έως ότου να φθάσει στο σημείο η γυναίκα εξέπνευσε.
Κατά τη νεκροψία-νεκροτομή ελήφθη και δείγμα, το οποίο σήμερα βγήκε θετικό στον κορονοϊό. Τα τρία παιδιά και ο σύζυγός της βρίσκονται σε κατ΄ οίκον περιορισμό, ενώ γίνονται προσπάθειες προκειμένου να βρεθούν οι επαφές που είχε η γυναίκα πριν καταλήξει.
![]()
Κορονοϊός: Νεκρή 40χρονη στην Καστοριά
Μία γυναίκα ηλικίας 40 ετών και μητέρα τριών παιδιών είναι το νεαρότερο θύμα του κορονοϊού στη χώρα μας....www.enikos.gr
Εγκληματικό για μένα.
Η γυναίκα απλά ακολούθησε αυτό που της είπαν.Έτσι φαίνεται.
Όμως ξαναλέω πλέον κάποιοι το μαζεύουν λέγοντας πως αν μετά την 5η μέρα δεν καλυτερεύουμε επικοινωνούμε με ΕΟΔΥ κοκ. Μόνο που δεν μπορούν να είναι όλοι 24 ωρες το 24ωρο σε όλα τα κανάλια για να βλέπουν τις αναθεωρήσεις των γιατρών.
Το γεγονός παραμένει ότι απο φόβο μήπως καταρρεύσει το σύστημα υγείας ελαστικοποίησαν κατά πολύ κάποια πράγματα. Αλλά πεθαίνουν άνθρωποι.
Γνώμη μου.
Σημείωση: Το μήνυμα αυτό γράφτηκε 5 χρόνια πριν. Ο συντάκτης του πιθανόν να έχει αλλάξει απόψεις έκτοτε.
than97
Νεοφερμένο μέλος


Αρχικά δεν έχουμε φτάσει επουδενί τους νεκρούς της εποχικής γρίπης. Όλοι είναι πολύ μακριά. Κατά δεύτερον δεν βλέπουμε τις ίδιες εικόνες με την εποχική γρίπη διότι υπάρχει εμβόλιο.Όλα αυτά τα σενάρια περι ανοσίας της αγέλης κλπ καταρρέουν απο την ίδια την πραγματικότητα.Που την βλέπουμε.
Δεν υπάρχει αυτό με την γρίπη δεν έχει καμία σχέση με τη γρίπη κάθε χρόνο και αυτό εδώ, ξαναλέω δεν βλέπουμε κάθε χρόνο να καταρρέουν τα συστήματα υγείας ούτε μας το κρύβει κανένας.
Και όσες χώρες άργησαν να λάβουν μέτρα καθώς ήταν διστακτικές για οικονομικούς λόγους και κάποιες εξέταζαν την ανοσία της αγέλης το μετάνιωσαν και έκαναν κωλοτούμπα και θα το μετανιώσουν ακόμα περισσότερο.Διότι αργησαν να τα πάρουν. Επίσης κάπου πήρε το αυτί μου ότι και η Σουηδία πλέον μπαίνει σε αυτή τη φάση αλλά δεν θυμάμαι που το είδα.Αν το βρω θα το βάλω.Ίσως να το άκουσα και στην τιβι.
Οπότε καλές αυτές οι θεωρίες αλλά άχρηστες πλεον διότι τις διαψεύδει η πραγματικότητα που ήδη ζούμε και όχι μελλοντικό σενάριο.
Αυτόματη ένωση συνεχόμενων μηνυμάτων:
Και πάνω που οι έρμοι είχαν μια μικρή αισιοδοξία.Δυστυχώς...
Το ίδιο ήταν και με τον H1N1 όταν πρωτοεμφανίστηκε μέχρι να εμφανιστούν τα εμβόλια.
Χωρίς τον ακριβή αριθμό κρουσμάτων δεν γνωρίζουμε την θνητότητα του covid, πιθανόν πολύ μικρότερη.
Για παράδειγμα στην Ελλάδα, εάν δεχθούμε το εύρος 8-10 χιλιάδες κρούσματα, τότε η θνησιμότητα του ιού είναι 0,2-0,25 %, αν μάλιστα είναι 50χιλιάδες είναι 0,04%. Οπότε ήδη είναι κάτω από 1% και κοντεύουμε στα επίπεδα της θνησιμότητας της γρίπης. Ωστόσο τα ελλιπή στατιστικά στοιχεία ( ο αριθμός που νοσούν), σε συνδυασμό με την απουσία τεστ , οδήγησαν στην απόφαση της καραντίνας της χώρας.
Η Ν. Κορέα, έχοντας περάσει μεγάλες πανωλεθρίες (2002), ενήργησε σύμφωνα με το μοντέλο της αγέλης και ακολούθησε τις οδηγίες του ΠΟΥ ΧΩΡΙΣ να μπει σε καραντίνα.
Η Σουηδία σήμερα πήρε μέτρο για τα μπαρ και τον τρόπο σερβιρίσματος του ποτού.
Στην χώρα βέβαια που έχει 20 νεκρούς σε 8-10 χιλιάδες κρούσματα μπήκε lockdown , προετοιμάζοντας μελλοντικά φέρετρα, πολλαπλάσια του COVID-19. Βέβαια αυτό δεν μας ενδιαφέρει μέχρι στιγμής...
Πόσο πιο δύσκολη θα ήταν μια καραντίνα των ευπαθών ομάδων ;
Σημείωση: Το μήνυμα αυτό γράφτηκε 5 χρόνια πριν. Ο συντάκτης του πιθανόν να έχει αλλάξει απόψεις έκτοτε.


Η πνευμονία καθεαυτή, είτε προκληθεί από τη γρίπη είτε από τον κορόνα βάηρους, έχει την ίδια αντιμετώπιση;
Σημείωση: Το μήνυμα αυτό γράφτηκε 5 χρόνια πριν. Ο συντάκτης του πιθανόν να έχει αλλάξει απόψεις έκτοτε.
Πουπουλίνα
Επιφανές μέλος


Μα δεν τόλμησαν να πουν ότι η γυναίκα δεν είχε αναφέρει το άσθμα της. Κανένας δεν το έχει πει αυτό.Δυσκολεύομαι να πιστέψω ότι αν η γυναίκα είχε όντως άσθμα δεν το είχε αναφέρει όταν πήρε τις οδηγίες για κατ' οίκον περιορισμό. Άρα για μία ακόμη φορά έχουμε άτομο που ανήκει στις ευπαθείς ομάδες να μην παραπέμπεται σε νοσοκομείο. Μπορεί τα μέσα να αναφέρουν το υποκείμενο νόσημα για να μην αγχωθούμε λόγω της ηλικίας της γυναίκας, αλλά η πιθανότητα να ισχύει αυτό που περιέγραψα είναι πιο τρομακτική και επικίνδυνη.
Η πνευμονία καθεαυτή, είτε προκληθεί από τη γρίπη είτε από τον κορόνα βάηρους, έχει την ίδια αντιμετώπιση;

Απλά τα μάσησαν αλλά τα γεγονότα παραμένουν. Η γυναίκα δεν είναι ότι δεν πήρε πουθενά τηλέφωνο δεν είναι ότι αδιαφόρησε και είπε έλα μωρέ. Έδρασε ακριβώς όπως έχουν πει. Πήρε τηλέφωνο στον ΕΟΔΥ και της είπαν να μέινει σπίτι .Όταν επιδεινώθηκε και κάλεσε ασθενοφόρο απλά ήταν αργά δεν την πρόλαβαν .
Έγκλημα για μένα και αυτό επειδή ελαστικοποίησαν το πότε πρέπει να πηγαίνουμε νοσοκομείο για να μην φορτωθούν.Είναι τόσο φανερό.
Νέα γυναίκα με 3 παιδιά.
Σημείωση: Το μήνυμα αυτό γράφτηκε 5 χρόνια πριν. Ο συντάκτης του πιθανόν να έχει αλλάξει απόψεις έκτοτε.
fockos
Επιφανές μέλος


Πολλοί ασθενείς ειδικά στα χωριά παρακολουθούνται στα νοσοκομεία από μη σταθερούς ιατρούς ή αραιά σε ιδιώτες ιατρους με συνχότητα μεγαλύτερη από από μία φορά το χρόνο.
Δεν ξέρω τι έγινε με την γυναικα οποτε δε μπορώ να εκφέρω άποψη αλλά καλό είναι όποιος έχει ΄τετοια προβλήματα να μην στηρίζεται στο νοσοκομείο αλλά σε ένα ιατρο που μπορεί να εχει άμεσα επαφή, όμως δεν είναι σωστό από την άλλη να κατηγορούμε ουτε τους ιατρούς, ουτε τον ΕΟΔΥ. Ο ΕΟΔΥ δεν λέει να μείνεις σπίτι λέει να μιλήσεις με το θεράποντα ιατρό.. ειδικά αν του λες για άσθμα.
Η κόρη της Βέφας που πέθανε πριν μερικά χρόνια είχε χρόνιο άσθμα πέθανε από γρίπη, όπως ειπε η ίδια η Βέφα ότι φέρει και η ιδια ευθύνη για τον θανατο της διότι δεν πήγαινε σε ιατρούς.
Τώρα αν πας στο νοσοκομείο κινδυνεύεις να κολλήσεις απο τους άλλους που περιμένουν αν δε πας κινδυνεύεις να χειροτερέψεις. Το σύστημα αυτό του ΕΟΔΥ έχει πολλές τρύπες που δεν αναφέρονται σκοπίμως από δημοσιογράφους....
Σημείωση: Το μήνυμα αυτό γράφτηκε 5 χρόνια πριν. Ο συντάκτης του πιθανόν να έχει αλλάξει απόψεις έκτοτε.
Scandal
Διαχειριστής

Χανταϊός: Ένας νεκρός άνδρας στην Κίνα - Καθησυχαστικοί οι ειδικοί | Documento
Σημείωση: Το μήνυμα αυτό γράφτηκε 5 χρόνια πριν. Ο συντάκτης του πιθανόν να έχει αλλάξει απόψεις έκτοτε.
juste un instant
Επιφανές μέλος



Βρετανία: Ανοίγει σε συνεδριακό κέντρο νοσοκομείο με 4.000 κλίνες - ΤΑ ΝΕΑ

Σημείωση: Το μήνυμα αυτό γράφτηκε 5 χρόνια πριν. Ο συντάκτης του πιθανόν να έχει αλλάξει απόψεις έκτοτε.
Χρήστες Βρείτε παρόμοια
-
Τα παρακάτω 0 μέλη και 14 επισκέπτες διαβάζουν μαζί με εσάς αυτό το θέμα:Tα παρακάτω 636 μέλη διάβασαν αυτό το θέμα:
- chester20080
- johnsala
- taketrance
- Scandal
- AggelikiGr
- Memetchi
- Paragontas7000
- giannhs2001
- Kate1914
- Wonderkid
- Searching
- fockos
- Hased Babis
- Entropy24
- Ωρορα
- Vera
- Sosstoss
- charmander
- Ilma
- American Economist
- back2967
- Μήτσος10
- giorgos5002
- User2350
- rafaela11
- many of Filip
- Unboxholics
- Αλκίμαχος
- bibliofagos
- iew
- Drscientist
- Giannismsn
- foxypup
- AN.PA
- Obi-Wan Kenobi
- Steven s
- Giorgkalo
- camil
- KGGS
- eukleidhs1821
- GeorgePap2003
- touvlo
- gademis
- A350
- fmarulezkd
- teacher_40
- Libertus
- fourkaki
- Αντικειμενικός
- Jack of Spades
- ghоul
- Joji
- synthnightingale
- linuxman
- Dr. Gl. Luminous
- еще один пророк р...
- Εριφύλη
- sixsixtysix
- Μαυρίκιος
- Γατέχων
- J.Cameron
- Maraki_lar_1980
- dmav
- Fernando_A
- phleidhs
- Antonia Alexandra
- chris91
- afantos
- marww
- jj!
- Ριουλα
- Dark_kronos
- lugar
- Indiana Jones
- Alessandra Eliza
- epote
- Δροσουλίτης
- Jim175
- MarcoReus
- Shadowban
- Στεφανος56
- Helen06
- Τodoroki
- PinkButterfly
- Maraki4you
- bigthor
- Ness
- Abiogenesis
- tsiobieman
- kalhkardia
- arko
- lepipini
- Metalhead_4_life
- Galini66
- Helen93
- Roulaki
- spring day
- ΘανάσοςG4
- vasilikileo1988
- Κλημεντίνη
- qwertyuiop
- ggl
- Εχέμυθη
- giorgos78
- ΛΑΡΑ7427
- Sevasti
- Meow
- Johnny15
- fretoe
- ΕυηΞ
- xristarac
- Citylights
- Ariana2018
- Γιάνννης Δ.
- Nina-nana
- Gpl37
- dimitra38
- Stres
- Αναστασία197
- louminis
- Freddys
- parrot/παπαγάλος
- Lathy
- Kassiopi
- Natalia143
- oups
- alexd99
- Ryuzaki
- ag97
- epan
- Cookie_Monster
- nicks1999
- bruh_234
- Lia 2006
- ]ifrit[
- JasonPap
- Giii
- don't touch
- Unseen skygge
- ougka pougka
- Dreamer_SW
- Nikoleta93
- Mt73
- m.kannavia3
- Stefania Geo
- hirasawayui
- Αρίκος
- vaspan
- Idontknoww
- johnietraf
- panamixagr97
- makis999
- 1011
- Jimmy20
- korlef
- Asterias21
- Selfcare
- Venom17
- Ismhnhpapa
- Therapeftis
- μανολης_
- l0garithm
- Alexandra Chatzin
- George9989
- L0st
- Appolon
- ΨΑΡΑΚΙ1993
- prinCess.
- chris2799
- ioannam
- SweetGirl
- dragonmind
- Agisilaos
- Αλκης Κ.
- Nickx
- ana.roi
- Atarax
- sofoula2430
- litsa2
- king_sotirios
- Stelios725
- CiNeFiL
- Viedo
- Lucifers
- VasoGrimes
- SlimShady
- Mhtrogoal
- Γέννηση20
- magdalicious
- tuaculpa:)
- Jocaste
- Γιώργος Ζ
- ΜαρίαΖΤ
- SonGokuUI
- Johnman97
- snowy
- desp1naa
- Dora140303
- aggelosst9
- Andreas542
- sayer
- menual
- GiorgosAsi
- Thundergirl
- Panos_02
- New member
- physicscrazy
- Μαρια30
- Ria99
- PanMoonlight
- What
- Douleutikos
- WhaleOilBeefHooked
- Γατόπαρδος.
- jims
- Machiavelian
- AK-92
- A propos
- kanenas
- T C
- constansn
- xrisamikol
- Φωτεινη Τζα.
- 0rafa0
- nicole1982
- sunsetpp
- edweimaste
- skot
- dimitrisfmf
- JimRav
- οθεσσαλονικιος
- πεταλουδα001
- Tsixris
- Thanasis7
- ιμοτζι
- Nefeli_
- 2Pac
- azula
- Slytherin
- Ροβερτα
- milianis
- tarantula
- Ace of Spades
- kostasidel
- gewrgia0298
- Kyc
- liaiscool
- p4n05
- Sense
- WhiteDrum
- Anna Glamorous
- Earthquake
- Le Champignon
- angelaras24
- romeo
- Chemwizard
- babycat
- jimis2001
- Tangible
- An_uknown_world
- kingkonstas
- Karim10
- Nala
- pacheiko
- TonyMontanaEse
- AaronStone
- gwgw_5
- niknik2002
- Cortes
- Αρχηγος_β3
- igeorgeoikonomo
- orange crush
- anastasis06
- imkindalost
- Blackmyrto
- Glorious26
- Loozen
- Insertcoin
- Rapappas
- provata
- Eua5
- Cupid
- Έμμα
- Ada ada
- Satan Claus
- CoolCowboy
- Elef8eria_Ad
- leo41
- norbit
- Lvh
- Sugarillo
- Freya Goddes
- iminspain
- Javier7
- globglogabgalab
- kiyoshi
- Panagiotis849
- LivingInTheFuture
- Demlogic
- Scott
- Comformist
- Eikosiduos
- EndstationWien
- Tsepeto
- RexkomGr
- Samuel
- Ευθυμος
- giadespoiamilaei
- RudiCaconi
- gregory nub
- Luke.
- orchidea
- Selenium
- IoanGreek
- το κοριτσι του μαη
- McManus
- ilektrakorovesi
- barkos
- Μιτοχονδριο
- malenaaa
- takefive
- Nikos 7
- Forgetit
- nickd
- Trolletarian
- φυσαλίς
- Mike1
- calliope
- riariaki_1990
- billie perrakis
- Mary Jane
- WayfaringStranger
- ιδιοτροπος
- don_vito
- Vindemiatrix
- meroliptiko gidi
- Giannis2307
- me lene
- GeorgiosMS
- Πέτρος Χουχούλης
- Πλάνης
- Awe
- Αναήλ
- GRland.info
- aye
- LeoDel
- Tzav
- konna
- Countdown
- pink_panther
- ManinaK
- Νηματολάγνος
- Liza19
- Dim1234
- Snoopy Doo
- kazlaris1
- Kostas98
- Fin4
- Toumpa
- soti_ko03
- uni77
- Pharmacist01
- Alexandros36k
- Αγάπη_Πλατωνική
- Griff
- Dr.
- Cpt.Philips
- Nikolas77
- ShadowS
- aytismos
- Denexeisidera
- Clio MTX
- elli russu
- gvarth
- Sokratis Mitropoulos
- Χαρουβιάν
- harry akritas
- SuperCandy
- David?
- Στωικος
- Galaxiarch
- kauphy
- Vold
- morpheas32
- Μάρκος Βασίλης
- kogba
- dimospap
- Angelo27
- kastoras
- εξ_άγγελος
- Φρεντος
- Hera167
- old man consequences
- Βλα
- Lydia6902
- anathimatikos
- Αnabell
- MarilynSt
- T20
- Stefanosxios
- Konstantinos_m
- Rene2004
- αιμοσταγές_χαμστεράκι
- yellowdust
- whitelioness
- grtt
- Ν.Χ.
- Μί–Κά-Ἔλ
- konstantinab199
- xzc213
- Pipitsa
- JohnGreek
- Kostis-Palamas
- nucomer
- element skate
- dazed
- Spooky29
- katelogic
- Elena345
- books_dreams_phane
- panagiotis G
- orestis_kritikos
- the impossible
- efi25
- Μορτάκι
- mallllias
- betonieras
- Power-13
- thanasiscb95
- SkyBlu
- jucticeee
- Μπλακ Πητ
- angel of death
- Duela Dent
- panagiotis econ
- "άσχημο_όνειρο"
- tymvorixos
- Σοφία Γιαννιού
- Σπυρακος (^^)
- Trolling Stones
- Μαριλένα__
- Alma
- Hyper_
- Μαρια43
- GoddamnRight
- eleni236
- Yiorgosk
- I_love_life
- darklady80
- star01
- tiktaktik
- κοσμοναύτης
-
Φορτώνει...
-
Το forum μας χρησιμοποιεί cookies για να βελτιστοποιήσει την εμπειρία σας.
Συνεχίζοντας την περιήγησή σας, συναινείτε στη χρήση cookies στον περιηγητή σας.